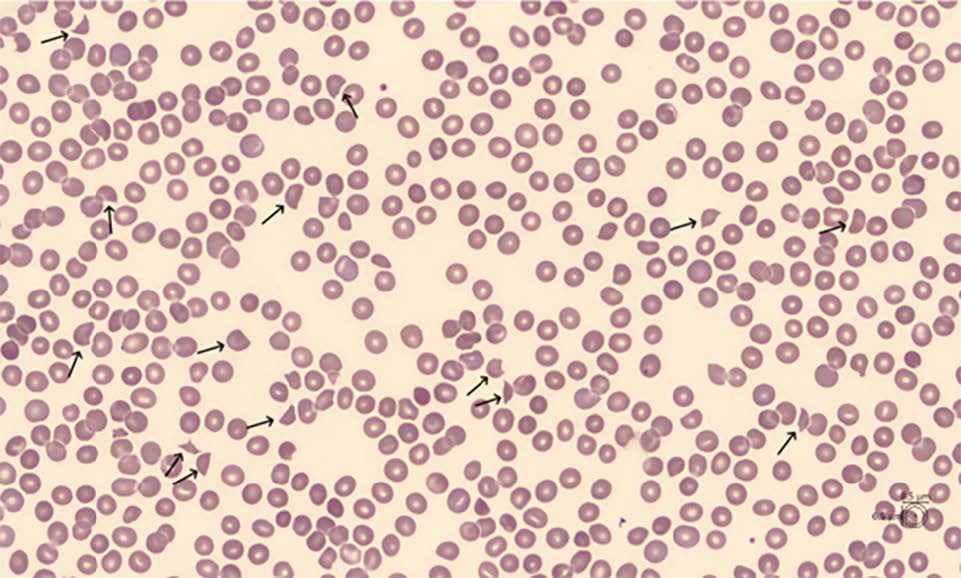

RÉSUMÉ
Nous rapportons le cas d’une femme de 53 ans admise aux urgences pour confusion et troubles de l’élocution. L’hémogramme a révélé une thrombocytopénie profonde (8 x 109/L) et une anémie (hémoglobine : 107 g/L). L’examen du frottis sanguin a mis en évidence 4 % de schizocytes. Les investigations de laboratoire ont montré une anémie hyperhémolytique, avec un niveau plasmatique d’haptoglobine indétectable (< 0,08 g/L ; valeurs de référence : 0,26-1,85 g/L) et une élévation des LDH (2 483 UI/L ; VR : 120-245 UI/L) ainsi qu’une insuffisance rénale aiguë (créatinine : 2,33 mg/dL ; VR : 0,52-1,04 mg/dL) et une concentration de troponines ultrasensibles très élevées (5 201 ng/L ; seuil < 9 ng/L). Ces résultats, dans un tel contexte clinique, ont évoqué un purpura thrombotique thrombocytopénique (PTT). Le PTT est une microangiopathie thrombotique (MAT) caractérisée par un déficit marqué en ADAMTS13, entraînant la formation de thrombi dans la microcirculation, responsables de la consommation des plaquettes et de la fragmentation des érythrocytes. Le diagnostic de PTT a été confirmé par une activité ADAMTS13 effondrée à 0,4 % (VR : 60-130 %) et par la présence d’anticorps anti-ADAMTS13 (53,57 U/mL ; seuil < 15 U/mL), précisant son origine auto-immune. Après l’initiation rapide d’un traitement, une nette amélioration clinique et biologique a été observée, avec la disparition des symptômes neurologiques, une amélioration de la numération plaquettaire, et une diminution des LDH. Ce cas clinique rappelle l’importance d’un diagnostic rapide du PTT, notamment grâce à la détection des schizocytes et à la mesure de l’ADAMTS13.MOTS CLÉS
ADAMTS13, microangiopathie, PTT, schizocytes, thrombocytopénie
ABSTRACT
We report the case of a 53-year-old woman admitted to the emergency department for confusion and speech impairment. The blood count revealed profound thrombocytopenia (8 x 109/L) and anemia (hemoglobin : 107 g/L). The peripheral blood smear revealed 4% schistocytes. Laboratory investigations showed hyperhemolytic anemia, with undetectable plasma haptoglobin (< 0,08 g/L ; normal range : 0,26-1,85 g/L) and markedly elevated LDH level (2 483 IU/L ; NR : 120-245 IU/L), as well as acute renal failure (creatinine : 2,33 mg/dL ; NR : 0,52-1,04 mg/dL) and significantly elevated concentration of high-sensitivity troponins (5 201 ng/L ; cut-off < 9 ng/L). Those results, in such a clinical context, were highly suggestive of thrombotic thrombocytopenic purpura (TTP). TTP is a thrombotic microangiopathy (TMA) characterized by a marked ADAMTS13 deficiency, leading to the formation of thrombi in the microcirculation, which results in platelet consumption and red cell fragmentation. TTP diagnosis was confirmed by a severely decreased ADAMTS13 activity, measured at 0,4% (NR : 60-130 %) and the presence of a high level of anti-ADAMTS13 antibodies (53,57 U/mL ; cut-off < 15 U/mL), indicating its autoimmune origin. After prompt treatment initiation, a marked improvement (both clinically and biologically) was observed, with resolution of neurological symptoms, normalization of the platelet count, and a decrease in LDH levels. This case highlights the importance of rapid diagnosis of TTP, particularly through schistocyte detection and ADAMTS13 assay.
KEYWORDS
ADAMTS13, microangiopathy, schistocytes, thrombocytopenia, TTP
CAS CLINIQUE
Une patiente de 53 ans a été admise aux urgences pour confusion aiguë. L’anamnèse étant difficile, son mari a rapporté l’apparition soudaine de cette confusion, accompagnée de troubles de l’élocution. La patiente a, quant à elle, signalé des nausées sans vomissements ni diarrhée, des épistaxis récents ainsi qu’une fièvre à 38 °C. Elle présentait des hématomes spontanés sur le torse et les jambes. Elle souffrait d’éthylisme chronique, pour lequel un sevrage volontaire avait récemment été initié avec l’aide de son médecin traitant, incluant une médication par diazépam et acamprosate. Elle n’avait pas d’autres antécédents médicaux significatifs.
Les investigations d’hémostase de laboratoire ont montré un temps de céphaline avec activateur (TCA – ou aPTT) (CK Prest, Diagnostica Stago) et un temps de Quick (Neoptimal 10, Diagnostica Stago) normaux. En revanche, les D-dimères, mesurés par immunoturbidimétrie (Liatest D-Di Plus, Diagnostica Stago), étaient à 11 560 ng/mL et le fibrinogène (méthode Clauss, Liquid Fib, Diagnostica Stago) à 6,37 g/L (valeurs de référence : 1,80-4,00 g/L).
Par ailleurs, la concentration de troponines ultrasensibles était fortement élevée (5 201 ng/L ; seuil < 9 ng/L) (immunoanalyse par chimiluminescence, QuidelOrtho). Sur le plan infectieux, la patiente était apyrétique et le bilan bactériologique était négatif.
Compte tenu des résultats de la numération sanguine, de l’âge de la patiente et des symptômes neurologiques, le diagnostic de purpura thrombotique thrombocytopénique (PTT), une forme de microangiopathie thrombotique (MAT), a été suspecté. Une recherche de schizocytes sur le frottis sanguin a donc été réalisée en urgence. L’examen du frottis a révélé 4 schizocytes pour 100 globules rouges (seuil de positivité > 1 %) (Figure 1), orientant vers une origine mécanique de l’anémie hémolytique. Les scores PLASMIC et French ont été utilisés pour estimer la probabilité d’un déficit sévère en ADAMTS13 (activité < 10 %). Chez cette patiente, le score PLASMIC était de 5, indiquant une probabilité de déficit sévère en ADAMTS13 comprise entre 5 % et 24 %.
Le score French était de 1, indiquant une probabilité de 70 %. Le diagnostic de PTT a été confirmé le jour même par la mise en évidence d’un déficit marqué de l’activité ADAMTS13 à 0,4 % en chimiluminescence (HemosIL AcuStar, Instrumentation Laboratory) (VR : 60-130 %). La présence d’anticorps anti-ADAMTS13 détectés par ELISA (Technozym INH, Technoclone) (53,57 U/mL ; seuil < 15 U/mL) a confirmé l’origine auto-immune du PTT (PTTi).
En résumé, les données cliniques et biologiques ont permis de retenir le diagnostic d’un PTT immunologique, reposant sur une activité ADAMTS13 effondrée (0,4 %), une thrombocytopénie sévère, une anémie hémolytique mécanique, une insuffisance rénale aiguë, et des atteintes cardiaque et neurologique.
Figure 1 : Frottis sanguin de la patiente, avec la présence de schizocytes (indiqués par les flèches).
Figure 1: Patient’s blood film, showing the presence of schistocytes (indicated by arrows).
PRISE EN CHARGE, ÉVOLUTION ET SUIVI DE LA PATIENTE
La patiente a été hospitalisée pendant dix jours, dont trois passés sous monitoring continu en unité de soins intensifs, avant son transfert dans le service d’hématologie. Sur le plan thérapeutique, elle a bénéficié d’un traitement associant du caplacizumab (un anticorps humanisé ciblant le domaine A1 du facteur von Willebrand), de la méthylprednisolone (corticothérapie) et du rituximab (un anticorps monoclonal ciblant le CD20).
Après 48 heures, la numération plaquettaire a augmenté de manière significative (passant de 8 x 109/L à 174 x 109/L), la fonction rénale s’est améliorée (créatininémie passant de 2,33 mg/dL à 1,84 mg/dL) et les LDH ont rapidement diminué (de 2 483 UI/L à 772 UI/L). Les symptômes neurologiques ont également disparu. Le scanner cérébral ne montrait pas de lésion endocrânienne aiguë. Malgré une élévation importante des troponines à l’admission (5 201 ng/L), l’électrocardiogramme ne montrait pas de signe d’ischémie aiguë myocardique. La troponinémie a progressivement diminué durant le séjour, pour atteindre 77,4 ng/L après une semaine. Ni transfusion, ni plasmaphérèse n’ont été nécessaires. L’évolution des résultats de l’hémogramme et de la biochimie sanguine à 48 heures et à la sortie est présentée respectivement dans les tableaux 1 et 2.
Le caplacizumab a été administré quotidiennement à la dose de 10 mg en sous-cutané, avec une dose intraveineuse initiale le jour de l’admission. Il a été poursuivi jusqu’à normalisation de l’activité ADAMTS13 (> 50 %) sur deux prélèvements consécutifs espacés d’au moins une semaine. Quinze jours après la sortie, celle-ci atteignait 58,9 %, puis 65 % une semaine plus tard, permettant l’arrêt du traitement. La corticothérapie par méthylprednisolone a débuté à 1 mg/kg/jour pendant 7 jours, puis a été réduite progressivement jusqu’à un arrêt complet un mois après l’hospitalisation. Le rituximab a été administré par voie intraveineuse à raison de 375 mg/m2/semaine pendant 4 semaines consécutives.
Un suivi ambulatoire hebdomadaire en hématologie a été programmé. Par ailleurs, une radiographie thoracique de contrôle et un scanner coronaire, réalisés dans les semaines suivant la sortie, se sont avérés rassurants. Le sevrage éthylique a été poursuivi sans complication durant l’hospitalisation, avec l’administration de diazépam et de vitamines du groupe B. Une psychothérapie de soutien a été proposée pour accompagner le maintien de l’abstinence.
Tableau 1 : Résultats de l’hémogramme à l’admission aux urgences (J0), après 48 heures (J2) et à la sortie (J10).
Table 1: Blood count results at admission to the emergency department (D0), after 48 hours (D2) and at discharge (D10).

Tableau 2 : Résultats de la biochimie sanguine à l’admission aux urgences (J0), après 48 heures (J2) et à la sortie (J10).
Table 2: Blood biochemistry results at admission to the emergency department (D0), after 48 hours (D2) and at discharge (D10).

DISCUSSION
Introduction et épidémiologie
Le purpura thrombotique thrombocytopénique (PTT) est une forme rare et grave de microangiopathie thrombotique (MAT), caractérisé par un déficit marqué en ADAMTS13, une métalloprotéase plasmatique qui clive les multimères de très grande taille du facteur de von Willebrand (vWF) (1). Dans plus de 90 % des cas, le PTT est d’origine immunologique (PTTi), causé par la présence d’auto-anticorps dirigés contre ADAMTS13. Le PTT congénital (PTTc), lié à une mutation dans la séquence du gène ADAMTS13, représente environ 10 % des cas (2-4). L’incidence du PTT est estimée à 2 à 4 cas par million de personnes par an (1). Le PTTi est plus fréquent chez les femmes (ratio F/H de 3:2), avec un âge médian de 40 ans (1).
Pathogenèse
Le déficit en ADAMTS13 entraîne l’accumulation de multimères de vWF de grande taille dans la micro-circulation. Sous l’effet des forces de cisaillement élevées dans la circulation artériolaire et capillaire, l’attachement des plaquettes à ces multimères de vWF ultra-larges (UL-vWF) déclenche une adhésion plaquettaire incontrôlée, suivie d’une agrégation et de la formation de thrombi microvasculaires dans presque tous les organes (1,3,4). Il en résulte une thrombocytopénie par consommation plaquettaire, une hémolyse intravasculaire avec fragmentation mécanique des globules rouges (générant des schizocytes) et des lésions ischémiques multiviscérales (3,4). Par rapport au syndrome hémolytique et urémique (SHU), ces thrombi sont plus largement répartis (cerveau, peau, rein, cœur…), reflétant la nature plus systémique du PTT (4).
Dans le PTTi, le déficit en ADAMTS13 peut résulter d’une activité enzymatique réduite et/ou d’une réduction de l’antigène circulant en fonction du mécanisme des auto-anticorps. Ainsi, les auto-anticorps anti-ADAMTS13 peuvent être inhibiteurs et/ou non-inhibiteurs. Les auto-anticorps inhibiteurs bloquent l’activité protéolytique de l’ADAMTS13 vis-à-vis du vWF, réduisant sa fonction, tandis que les auto-anticorps non inhibiteurs ne bloquent pas directement l’activité enzymatique mais peuvent contribuer à une déficience en accélérant son élimination du plasma (par la formation de complexes immuns antigène-anticorps ADAMTS13), ou en perturbant sa synthèse ou sa sécrétion (4,5). La réponse auto-immune contre ADAMTS13 est polyclonale et hétérogène. Les auto-anticorps anti-ADAMTS13 sont pour la plupart des IgG et reconnaissent le plus souvent le domaine riche en cystéine/Spacer (CS), soulignant l’importance de cette région pour l’activité fonctionnelle de l’ADAMTS13 (2,5).
Présentation clinique
Les MAT associent thrombocytopénie, anémie hémolytique et atteinte d’organes (1,3,4). Le PTT est une forme de MAT qui se manifeste par une thrombocytopénie sévère et des atteintes multiviscérales (3,4). Les manifestations cérébrales et digestives sont les plus fréquentes (1). Plus de 80 % des patients présentent des troubles neurologiques, allant des céphalées à de la confusion, en passant par l’accident vasculaire cérébral (AVC) ou l’altération de l’état de conscience (3). L’ischémie gastro-intestinale peut entraîner douleurs abdominales, nausées et diarrhée (6). En raison de leur gravité, les complications cardiaques du PTT (infarctus du myocarde, insuffisance cardiaque, arythmies) méritent une attention toute particulière. Des taux élevés de troponine sérique au diagnostic, observés chez près de 60 % des patients, sont associés à un risque accru de mortalité et de résistance au traitement (3,7). Bien que la présentation clinique soit d’apparition brutale, des symptômes prodromiques tels que fatigue, arthralgies, myalgies, douleurs abdominales et/ou lombaires évoquant un syndrome pseudo-grippal sont fréquents (1). Le tableau clinico-biologique initial du PTT est peu spécifique, mais le déficit sévère acquis en ADAMTS13 est typiquement associé à une atteinte rénale modérée et une thrombocytopénie sévère, permettant de distinguer le PTT des autres MAT (1,4).
Diagnostic en laboratoire
En cas de suspicion de MAT, il est essentiel d’examiner rapidement le frottis sanguin pour rechercher la présence de schizocytes (8,9). Ceux-ci présentent des critères morphologiques précis : ils sont toujours plus petits que les globules rouges intacts et, dans la plupart des cas, colorés de manière homogène, avec au moins un angle aigu. Ils peuvent se présenter sous la forme de kératocytes (fragments de globules rouges), de cellules en casque ou de schizocytes en triangle. Les microsphérocytes sont comptés comme schizocytes lorsque les formes classiques de schizocytes sont observées (8). Le pourcentage de schizocytes doit être évalué sur au moins 1 000 hématies. Selon les recommandations du Conseil International pour la Standardisation en Hématologie (ICSH), il est considéré comme significatif lorsqu’il dépasse 1 % chez les adultes et nouveau-nés à terme et 5 % chez les nouveau-nés prématurés (8). Bien que la présence de schizocytes oriente fortement vers une MAT, leur absence ne permet pas d’exclure ce diagnostic (8). Les compteurs d’hématologie détectent les schizocytes à l’aide d’alarmes ou de comptages de fragments de globules rouges (FRC) basés sur des critères de taille bien définis par rapport aux érythrocytes intacts. Les dernières lignes directrices de l’ICSH suggèrent que les résultats de FRC sont utiles comme test de dépistage pour l’évaluation des schizocytes (8).
L’absence de FRC permet d’exclure leur présence, sauf lorsque le volume globulaire moyen est élevé (8). Les microscopes automatisés détectent efficacement les schizocytes. Dans tous les cas, une confirmation au microscope optique par un hématologiste ou un technicien qualifié reste indispensable (8).
Le diagnostic différentiel rapide entre le PTT et d’autres formes de MAT, comme le SHU, est essentiel pour mettre en place un traitement adapté en urgence. En raison de la difficulté à différencier les MAT sur la seule base de la présentation clinique (3), les scores PLASMIC et French ont été développés. Ces scores permettent d’évaluer la probabilité d’un déficit sévère en ADAMTS13 chez les patients suspectés d’avoir un PTT, ce qui permet d’effectuer un diagnostic probabiliste précoce et ainsi d’éviter les retards dans l’initiation du traitement (1,4,10). Cependant, ces scores ont été développés et validés chez des populations adultes sans comorbidités, telles que la grossesse, un cancer, un sepsis, une transplantation ou encore une coagulation intravasculaire disséminée (CIVD), ce qui limite leur fiabilité dans ces contextes cliniques (1,10). Les critères pris en compte par ces scores sont détaillés dans le tableau 3.
La mesure de l’activité ADAMTS13 démontrant un déficit sévère, défini par un niveau d’activité < 10 %, est indispensable pour confirmer le diagnostic de PTT (1,2,4,10). Tout retard dans le rendu de ce résultat impacte négativement le pronostic (1). à noter qu’une baisse de l’activité ADAMTS13 peut aussi survenir dans d’autres situations (cancer métastatique, septicémie, CIVD, maladie hépatique, grossesse) (3). La mesure de l’activité ADAMTS13 s’effectue sur plasma, à l’aide d’un substrat vWF complet ou, plus couramment, de fragments synthétiques de vWF. Les produits de clivage sont alors quantifiés par ELISA (3,11). Le test d’activité ADAMTS13 réalisé sur l’HemosIL AcuStar®, basé sur la chimiluminescence, offre une analyse plus rapide (résultat rendu en moins d’une heure), avec une sensibilité de 98 % (intervalle de confiance à 95 % : 0,94-1,00) et une spécificité de 99 % (intervalle de confiance à 95 % : 0,97-1,00) (12).
L’ELISA permet de détecter les auto-anticorps anti ADAMTS13 (qu’ils soient neutralisants ou non) et de confirmer l’origine auto-immune du PTT. Bien que sensible, ce test présente une moindre spécificité, car des auto-anticorps non neutralisants peuvent également être
retrouvés chez des sujets sains ou dans d’autres pathologies auto-immunes, telles que le lupus érythémateux disséminé (LED) ou le syndrome des antiphospholipides (SAPL) (5).
Tableau 3 : Les scores PLASMIC et French prédisent la probabilité d’un déficit sévère en ADAMTS13 en cas de suspicion de PTT. Ces scores intègrent plusieurs critères tels qu’une thrombocytopénie sévère (< 30×109/L), une atteinte rénale légère (créatinine sérique < 2,25 mg/dL), des signes d’anémie hémolytique (haptoglobine effondrée, bilirubine indirecte > 2 mg/dL, réticulocytes > 2,5 %), ou encore un INR bas. Chaque élément est associé à un point (+1). Adapté de (1,10)
Table 3: The PLASMIC and French scores predict the probability of severe ADAMTS13 deficiency in cases of suspected TTP. These scores include several criteria such as severe thrombocytopenia (< 30×109/L), mild renal impairment (serum creatinine < 2,25 mg/dL), signs of hemolytic anemia (collapsed haptoglobin, indirect bilirubin > 2 mg/dL, reticulocytes > 2,5 %), and low INR. Each item is associated with one point (+1). Adapted from (1,10)

Prise en charge et traitement
En l’absence de traitement, la mortalité du PTTi dépasse 90 % (6). Le PTTi constitue dès lors une urgence vitale nécessitant un diagnostic rapide et une prise en charge spécialisée (2,3). Le traitement repose sur la plasmaphérèse, l’immunosuppression à base de corticostéroïdes et
l’immunothérapie ciblée, notamment le rituximab, un anticorps monoclonal humanisé anti-CD20, et le caplacizumab, un anticorps humanisé dirigé contre le domaine A1 du vWF, efficace dans la phase initiale de formation des microthrombi en inhibant l’interaction entre les
multimères du vWF et les plaquettes (1,4,9,10). Le rituximab est administré dès la phase aiguë selon un schéma de perfusion de 375 mg/m² par semaine pendant 4 semaines, afin d’inhiber la production d’auto-anticorps anti-ADAMTS13 (2,3). Le caplacizumab accélère la normalisation de la numération plaquettaire et réduit l’incidence des exacerbations car il est généralement poursuivi pendant 30 jours après l’arrêt de la plasmaphérèse, couvrant ainsi la période à risque de rechute (1).
Pronostic et suivi à long terme
Le pronostic du PTTi dépend fortement de la rapidité du diagnostic et de l’initiation du traitement (1,3,6). Lorsqu’il est pris en charge rapidement et de manière adaptée, le taux de survie atteint environ 90 à 95 % (2,6). Le suivi à long terme reste complexe, car 40 % des patients présenteront au moins une rechute (1). Une activité ADAMTS13 < 10-20 % en rémission constitue un facteur prédictif majeur (3,6), justifiant un suivi mensuel pendant 3 mois, puis trimestriel pendant un an, et enfin tous les 6 à 12 mois si elle est stable (6). En cas de diminution persistante liée la réapparition d’auto-anticorps, un traitement préemptif par rituximab devra être instauré afin de prévenir une rechute et restaurer l’activité ADAMTS13 (13). Outre le risque de rechute, le PTT expose à des complications à long terme. Plus de 50 % des patients de plus de 40 ans ayant survécu à l’épisode aigu présentent une morbidité majeure au cours du suivi (AVC, insuffisance rénale nécessitant une dialyse et/ou atteintes cardiaques sévères) ainsi qu’un risque accru de mortalité cardiovasculaire (4).
POINTS CLÉS À RETENIR
• En cas de suspicion de MAT, il est essentiel d’examiner rapidement le frottis sanguin pour rechercher la présence de schizocytes. Un nombre de schizocytes > 1 % confirme en effet une MAT chez l’adulte ou le nouveau-né à terme (> 5 % chez le prématuré), bien que leur absence n’exclue pas le diagnostic.
• Les scores PLASMIC et French aident à estimer rapidement la probabilité d’un déficit sévère en ADAMTS13, facilitant un diagnostic rapide du PTT et une prise en charge adaptée. Cependant, ces scores ne sont validés que chez l’adulte sans comorbidités majeures (cancer, sepsis, transplantation, CIVD).
• Un déficit marqué de l’activité ADAMTS13 (< 10 %) est nécessaire pour confirmer le diagnostic de PTT. Le test doit être effectué en urgence, car tout retard de traitement peut compromettre le pronostic vital.
• La mise en évidence d’auto-anticorps anti-ADAMTS13 confirme la nature immunologique du PTT (PTTi) et permet de le distinguer du PTT constitutionnel (forme héréditaire).

